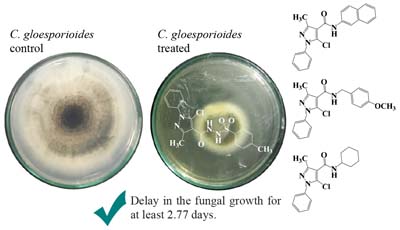

vol. 31, No. 9, 2020, p. 1759-1963
The 2-amino-1,4-naphthoquinone derivatives are interesting and versatile compounds with relevant biological activity, including antibacterial activity. The most significant effect was observed against Klebsiella pneumoniae positive β-lactamase. In addition, the experimental and theoretical affinity of the three most potential bactericidal compounds with human serum albumin indicated spontaneous and moderate interaction, which makes it possible to transport them in the human bloodstream. Details are presented in the Article Antibacterial Activity of 2-Amino-1,4-naphthoquinone Derivatives against Gram-Positive and Gram-Negative Bacterial Strains and Their Interaction with Human Serum Albumin by Carla C. da Silva, Otávio A. Chaves, Rojane O. Paiva, Gisela L. da Costa, José Carlos Netto-Ferreira and Aurea Echevarria on page 1838.
Antibacterial Activity of 2-Amino-1,4-naphthoquinone Derivatives against Gram‑Positive and Gram-Negative Bacterial Strains and Their Interaction with Human Serum Albumin
Carla C. da Silva; Otávio A. Chaves  ; Rojane O. Paiva; Gisela L. da Costa; José Carlos Netto-Ferreira; Aurea Echevarria
; Rojane O. Paiva; Gisela L. da Costa; José Carlos Netto-Ferreira; Aurea Echevarria

The 2-amino-1,4-naphthoquinone derivatives are interesting and versatile compounds with relevant biological activity, including antibacterial activity. The most significant effect was observed against Klebsiella pneumoniae positive β-lactamase. In addition, the experimental and theoretical affinity of the three most potential bactericidal compounds with human serum albumin indicated spontaneous and moderate interaction, which makes it possible to transport them in the human bloodstream. Details are presented in the Article Antibacterial Activity of 2-Amino-1,4-naphthoquinone Derivatives against Gram-Positive and Gram-Negative Bacterial Strains and Their Interaction with Human Serum Albumin by Carla C. da Silva, Otávio A. Chaves, Rojane O. Paiva, Gisela L. da Costa, José Carlos Netto-Ferreira and Aurea Echevarria on page 1838.
https://dx.doi.org/10.21577/0103-5053.20200070
Communication J. Braz. Chem. Soc. 2020, 31(9), 1759-1763
Determination of Ethanol in Gel Hand Sanitizers Using Mid and Near Infrared Spectroscopy
Fernando S. Fonseca Jr.; Lívia R. e Brito  ; Maria Fernanda Pimentel; Leila B. Leal
; Maria Fernanda Pimentel; Leila B. Leal

Two methods based on mid and near infrared spectroscopy associated with chemometrics were developed to determine ethanol content in alcohol-based gel hand-sanitizers.
https://dx.doi.org/10.21577/0103-5053.20200115
J. Braz. Chem. Soc. 2020, 31(9), 1764-1770
Drawing Electrochemical Sensors Using a 3D Printing Pen
Rafael M. Cardoso; Sílvia V. F. Castro  ; Jéssica S. Stefano
; Jéssica S. Stefano  ; Rodrigo A. A. Muñoz
; Rodrigo A. A. Muñoz

We demonstrate that a 3D printing pen (commonly used as a toy for kids) can be used to the fast drawing of low-cost electrochemical thermoplastic sensors in any desirable design using conductive filaments.
https://dx.doi.org/10.21577/0103-5053.20200129
Articles J. Braz. Chem. Soc. 2020, 31(9), 1771-1777
New Strategy for Streptavidin Detection Using AuNRs/PAAm Hydrogel Composites
Jean H. de Oliveira; Johny P. Monteiro; Paulo H. M. Buzzetti  ; Bento P. Cabral Jr.; Eduardo Radovanovic
; Bento P. Cabral Jr.; Eduardo Radovanovic  ;
;
Emerson M. Girotto

The figure presents a new hydrogel/gold nanorods system for the detection of streptavidin by specific interaction using the localized surface plasmon resonance (LSPR) phenomenon.
https://dx.doi.org/10.21577/0103-5053.20200032
J. Braz. Chem. Soc. 2020, 31(9), 1778-1786
A Highly Selective Fluorescent Chemosensor for Al3+ Based on 2,2':6',2"-Terpyridine with a Salicylal Schiff Base
Jiacheng Xu; Hui Li  ; Liangwei Li; Jianzhi Wang; Feng Wang; Luying He
; Liangwei Li; Jianzhi Wang; Feng Wang; Luying He

New 2,2':6',2"-terpyridines-derived Schiff base chemosensors (TPySSB) for the highly selective determination of Al3+ in ethanol.
https://dx.doi.org/10.21577/0103-5053.20200063
J. Braz. Chem. Soc. 2020, 31(9), 1787-1795
Zinc Hexacyanoferrate/Multi-Walled Carbon Nanotubes Films for Rechargeable Aqueous Batteries
Murillo N. T. Silva  ; José D. Ardisson; José D. Fabris; Edson Nossol
; José D. Ardisson; José D. Fabris; Edson Nossol

Multi-walled carbon nanotube/zinc hexacyanoferrate (MWCNT/ZnHCF) battery electrode based on interfacial synthesis promotes intimate contact between the components with good electrical conductivity, and an increasing of eight-fold in the electrode capacity compared with ZnHCF electrode.
https://dx.doi.org/10.21577/0103-5053.20200064
J. Braz. Chem. Soc. 2020, 31(9), 1796-1804
Mechanistic Investigation of DBU-Based Ionic Liquids for Aza-Michael Reaction: Mass Spectrometry and DFT Studies of Catalyst Role
Augusto A. Cândido; Thiago C. Rozada; Andrew M. F. Rozada; João R. B. Souza; Eduardo J. Pilau  ; Fernanda A. Rosa; Ernani A. Basso
; Fernanda A. Rosa; Ernani A. Basso  ; Gisele F. Gauze
; Gisele F. Gauze

Acid hydrogen in the ionic liquid (IL) and the ability of the anion to carry out a hydrogen bond with arylamine are fundamental for the catalysis.
https://dx.doi.org/10.21577/0103-5053.20200066
J. Braz. Chem. Soc. 2020, 31(9), 1805-1814
Synthesis and Evaluation of Nematicidal Activity of Compounds Derived from Norbornadiene
Anni C. S. Gomes; Antonio J. Demuner  ; Elson S. Alvarenga
; Elson S. Alvarenga  ; João P. E. Gondim; Andressa R. Fonseca; Dalila S. Buonicontro; Eduardo J. Pilau
; João P. E. Gondim; Andressa R. Fonseca; Dalila S. Buonicontro; Eduardo J. Pilau  ; Evandro Silva
; Evandro Silva

Norbornadiene derivatives, infested roots, nematode live and nematode dead.
https://dx.doi.org/10.21577/0103-5053.20200067
J. Braz. Chem. Soc. 2020, 31(9), 1815-1824
Synthesis, Characterization, Absorption and Fastness Properties of Novel Monoazo Dyes Derived from 1-Phenyl-3-amino-4-(2-thiazolilazo)pyrazol-5-one
How to cite this article

The absorption values (λmax) of synthesised dyes were not related to the polarity of solvents but instead to the proton-donor and acceptor properties of solvents, which reinforced the ionisation rather than tautomerism and they were more sensitive towards acids. The dyes may be in cationic and anionic form totally or partially in acidic and basic medium. The image shows the tautomeric structures and ionic forms of 1-phenyl-3-amino-4-(2-thiazolilazo)pyrazol-5-one.
https://dx.doi.org/10.21577/0103-5053.20200068
J. Braz. Chem. Soc. 2020, 31(9), 1825-1837
Phytochemical Analysis, Multi-Element Composition and Biological Activities of Extracts and Lupenone from Albizia inundata (Mart.) Barneby & J.W.Grimes
Eberson M. J. Andrade; Jéssica S. Teixeira; Dahara K. C. Silva; Tatiana B. dos Santos; Maria G. A. Korn; Hugo N. Brandão; Caline G. Ferraz; Cássio S. Meira; Milena B. P. Soares; Elisava T. Guimarães; Lourdes C. S. Neta; Aníbal F. S. Júnior

Lupenone was isolated, for the first time, from Albizia inundata (Mart.) Barneby & J.W.Grimes by one-dimensional nuclear magnetic resonance. Extracts and lupenone from A. inundata showed antimicrobial (antibacterial, antifungal and antiparasitic) activities and, multi-element composition was evaluated using inductively coupled plasma optical emission spectrometry (ICP OES).
https://dx.doi.org/10.21577/0103-5053.20200069
J. Braz. Chem. Soc. 2020, 31(9), 1838-1851
Antibacterial Activity of 2-Amino-1,4-naphthoquinone Derivatives against Gram‑Positive and Gram-Negative Bacterial Strains and Their Interaction with Human Serum Albumin
Carla C. da Silva; Otávio A. Chaves  ; Rojane O. Paiva; Gisela L. da Costa; José Carlos Netto-Ferreira; Aurea Echevarria
; Rojane O. Paiva; Gisela L. da Costa; José Carlos Netto-Ferreira; Aurea Echevarria

A series of 2-amino-1,4-naphthoquinone derivatives (NQA-NQF) was evaluated as potential antibacterial. NQF was identified as the most active compound against K. pneumoniae positive β-lactamase (minimum inhibitory concentration (MIC) = 31.2 µg mL-1) and presented good parameters of interaction with human serum albumin (HSA).
https://dx.doi.org/10.21577/0103-5053.20200070
J. Braz. Chem. Soc. 2020, 31(9), 1852-1858
Crystallographic Changes Accompanying the Verwey Transition in a Magnetite from Steatite
Fernando D. da Silva  ; Sandra L. Nogueira
; Sandra L. Nogueira  ; José D. Fabris; Antônio T. Goulart; Paulo R. C. Couceiro
; José D. Fabris; Antônio T. Goulart; Paulo R. C. Couceiro

The scanning electron microscopy image shows a magnetite crystal of natural origin. In the X-ray diffraction it is possible to visualize the crystalline transition of this magnetite at low temperature (15 K). Highlighted the evolution of the Verwey transition as a function of temperature and its change from cubic to monoclinic structure.
https://dx.doi.org/10.21577/0103-5053.20200073
J. Braz. Chem. Soc. 2020, 31(9), 1859-1872
Accessing Basic Sites on Modified CoFe2O4 Nanoparticles: Addressing the Selective Oxidation of Benzyl Alcohol and Unraveling the Au:Pd Ratio Effects by XPS
Laíse N. S. Pereira; Marco A. S. Garcia  ; Jennifer Rozendo; Pedro Vidinha; Alfredo Duarte
; Jennifer Rozendo; Pedro Vidinha; Alfredo Duarte  ; Carla V. R. de Moura
; Carla V. R. de Moura  ; Edmilson M. de Moura
; Edmilson M. de Moura

AuPd nanoparticles were immobilized onto a basic CoFe2O4-modified magnetic support and presented remarkable activity/selectivity on oxidation reactions.
https://dx.doi.org/10.21577/0103-5053.20200075
J. Braz. Chem. Soc. 2020, 31(9), 1873-1882
Electroanalytical Method for Determination of Trace Metals in Struvite Using Electrochemically Treated Screen-Printed Gold Electrodes
Maria L. S. Vasconcellos; Diego P. Rocha; Sílvia V. F. Castro; Luiz R. G. Silva; Rodrigo A. A. Muñoz  ; Marcos B. J. G. Freitas; Rafael Q. Ferreira
; Marcos B. J. G. Freitas; Rafael Q. Ferreira

This study presents a new electrochemical method for determination of trace metals (PbII, CuII and HgII) in struvite samples (natural fertilizer produced from urine). For this, we propose the use of square-wave anodic stripping voltammetry (SWASV) technique associated with electrochemically treated screen-printed gold electrodes.
https://dx.doi.org/10.21577/0103-5053.20200081
J. Braz. Chem. Soc. 2020, 31(9), 1883-1890
Omega-3 and Omega-6 Determination in Nile Tilapia's Fillet Based on MicroNIR Spectroscopy and Multivariate Calibration
Dayane A. dos Santos; Aline Coqueiro  ; Thays R. Gonçalves; Jonathan C. Carvalho; Jailton S. Bezerra Jr.; Makoto Matsushita; Carlos A. L. de Oliveira; Paulo H. Março; Patrícia Valderrama
; Thays R. Gonçalves; Jonathan C. Carvalho; Jailton S. Bezerra Jr.; Makoto Matsushita; Carlos A. L. de Oliveira; Paulo H. Março; Patrícia Valderrama  ; Ricardo P. Ribeiro
; Ricardo P. Ribeiro

Near-infrared/partial least squares (NIR/PLS) calibration developed to predict omega-3 and omega-6 in fillets of Nile tilapias packed under vacuum.
https://dx.doi.org/10.21577/0103-5053.20200082
J. Braz. Chem. Soc. 2020, 31(9), 1891-1897
Effects of Temperature and Concentration on the Determination of PET Viscosity
Felipe Z. da Silva  ; Izabella C. Bastos; Daniela B. Hirata
; Izabella C. Bastos; Daniela B. Hirata

The work consisted of an analytical investigation, based on statistical concepts, to validate a model that described the viscosity of a polymeric polyethylene terephthalate (PET) solution.
https://dx.doi.org/10.21577/0103-5053.20200084
J. Braz. Chem. Soc. 2020, 31(9), 1898-1907
Optimization and Validation of LLE-LTP and QuEChERS Methodologies for Determining 2,4-D in Water Samples
Lucas V. P. Freitas  ; Lázaro C. Sicupira; Gevany P. Pinho; Flaviano O. Silvério
; Lázaro C. Sicupira; Gevany P. Pinho; Flaviano O. Silvério

Graphical abstract represents liquid-liquid extraction with low-temperature partition (LLE-LTP) and quick, easy, cheap, effective, rugged, and safe (QuEChERS) methodologies combined with high-performance liquid chromatography with diode array detector (HPLC-DAD) used in the present study for determining 2,4-dichlorophenoxyacetic acid (2,4-D) in water samples.
https://dx.doi.org/10.21577/0103-5053.20200086
J. Braz. Chem. Soc. 2020, 31(9), 1908-1916
Dereplication of Aporphine Alkaloids by UHPLC-HR-ESI-MS/MS and NMR from Duguetia lanceolata St.-Hil (Annonaceae) and Antiparasitic Activity Evaluation
Erick P. Dantas; Jackson Monteiro; Lívia S. de Medeiros; Maiara M. Romanelli; Maiara Amaral; Andre G. Tempone; João Henrique G. Lago  ; Marisi G. Soares; Patricia Sartorelli
; Marisi G. Soares; Patricia Sartorelli

The dereplication of alkaloidic phase from Duguetia lanceolata performed by ultra-high performance liquid chromatography high resolution electrospray ionization tandem mass spectrometry (UHPLC-HR-ESI-MS/MS) and 1H nuclear magnetic resonance (NMR) allowed the identification of eight aporphine alkaloids. Some fraction composed by alkaloids show antiparasitic activity.
https://dx.doi.org/10.21577/0103-5053.20200089
J. Braz. Chem. Soc. 2020, 31(9), 1917-1925
Synthesis and Evaluation of the Fungal Activity of New Pyrazole-Carboxamides against Colletotrichum gloeosporioides
Edwin González-López; Jhair León-Jaramillo; Jorge Trilleras  ; Carlos D. Grande-Tovar; Yeimmy Peralta-Ruiz; Jairo Quiroga
; Carlos D. Grande-Tovar; Yeimmy Peralta-Ruiz; Jairo Quiroga
Influence of four pyrazole-carboxamide derivatives in parameters growth of C. gloeosporioides BA3 in potato dextrose agar (PDA).
https://dx.doi.org/10.21577/0103-5053.20200092
J. Braz. Chem. Soc. 2020, 31(9), 1926-1938
Profiling the Cymbopogon nardus Ethanol Extract and Its Antifungal Potential against Candida Species with Different Patterns of Resistance
Luciani G. de Toledo  ; Matheus A. S. Ramos
; Matheus A. S. Ramos  ; Larissa Spósito
; Larissa Spósito  ; Elza M. Castilho
; Elza M. Castilho  ; Fernando R. Pavan
; Fernando R. Pavan  ; Érica O. Lopes
; Érica O. Lopes  ; Isabel C. da Silva
; Isabel C. da Silva  ; Guilherme J. Zocolo
; Guilherme J. Zocolo  ; Paulo R. V. Ribeiro
; Paulo R. V. Ribeiro  ; Fernando B. Oda
; Fernando B. Oda  ; Juhan A. S. Pereira; André G. dos Santos
; Juhan A. S. Pereira; André G. dos Santos  ; Taís M. Bauab
; Taís M. Bauab  ; Margarete T. G. de Almeida
; Margarete T. G. de Almeida

Ethanol extract from leaves of Cymbopogon nardus (citronella) contains phenolic compounds that exerted significant antifungal activity.
https://dx.doi.org/10.21577/0103-5053.20200093
J. Braz. Chem. Soc. 2020, 31(9), 1939-1948
Lignocellulosic Residues from the Brazilian Juice Processing Industry as Novel Sustainable Sources for Bioenergy Production: Preliminary Assessment Using Physicochemical Characteristics
José L. F. Alves  ; Emmely O. da Trindade; Jean C. G. da Silva
; Emmely O. da Trindade; Jean C. G. da Silva  ; Guilherme D. Mumbach
; Guilherme D. Mumbach  ; Ricardo F. Alves
; Ricardo F. Alves  ; José M. Barbosa Filho
; José M. Barbosa Filho  ; Petrônio F. de Athayde-Filho; Rennio F. de Sena
; Petrônio F. de Athayde-Filho; Rennio F. de Sena

Underutilized lignocellulosic residues from the Brazilian juice processing industry as promising feedstocks in thermochemical processes.
https://dx.doi.org/10.21577/0103-5053.20200094
J. Braz. Chem. Soc. 2020, 31(9), 1949-1954
Polyurethanes Obtained by Reacting 1,6-HDI with Monoglycerides from Babassu Oil: A DFT Study
Francisco I. da Silva; Égil Sá  ; José M. E. de Matos
; José M. E. de Matos

Polyurethane by reacting 1,6-hexamethylenediisocyanate (1,6-HDI) with 2-monolaurin, which is the most abundant monoacylglycerol in the babassu oil, occurs by a concerted mechanism. The polymerization occurs by adding urethane monomer, instead of each of the co-monomer.
https://dx.doi.org/10.21577/0103-5053.20200096
Short Report J. Braz. Chem. Soc. 2020, 31(9), 1955-1963
Evaluation of Brazilian Monovarietal Extra Virgin Olive Oils Using Digital Images and Independent Component Analysis
Thays R. Gonçalves; Larissa N. Rosa; Paulo H. Março; Luiz F. O. da Silva; Sandra T. M. Gomes; Makoto Matsushita; Patrícia Valderrama

Brazilian monovarietal extra virgin olive oil: an unsupervised pattern recognition approach based on red, green and blue (RGB) channels and independent component analysis.
https://dx.doi.org/10.21577/0103-5053.20200083
Online version ISSN 1678-4790 Printed version ISSN 0103-5053
Journal of the Brazilian Chemical Society
JBCS Editorial and Publishing Office
University of Campinas - UNICAMP
13083-970 Campinas-SP, Brazil
Free access










